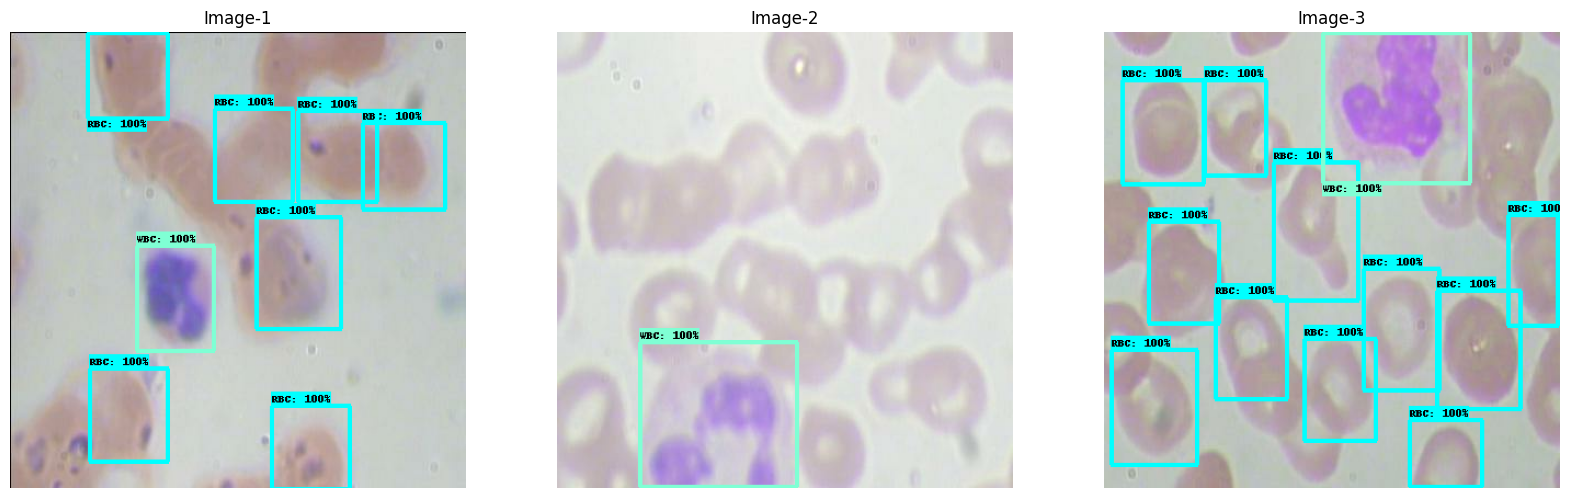
png

View on TensorFlow.org
|
Run in Google Colab
|
View on GitHub
|
Download notebook
|
This tutorial fine-tunes a RetinaNet with ResNet-50 as backbone model from the TensorFlow Model Garden package (tensorflow-models) to detect three different Blood Cells in BCCD dataset. The RetinaNet is pretrained on COCO train2017 and evaluated on COCO val2017
Model Garden contains a collection of state-of-the-art models, implemented with TensorFlow's high-level APIs. The implementations demonstrate the best practices for modeling, letting users to take full advantage of TensorFlow for their research and product development.
This tutorial demonstrates how to:
- Use models from the Tensorflow Model Garden(TFM) package.
- Fine-tune a pre-trained RetinanNet with ResNet-50 as backbone for object detection.
- Export the tuned RetinaNet model
Install necessary dependencies
pip install -U -q "tf-models-official"Import required libraries
import os
import io
import pprint
import tempfile
import matplotlib
import numpy as np
import tensorflow as tf
import matplotlib.pyplot as plt
from PIL import Image
from six import BytesIO
from IPython import display
from urllib.request import urlopen
2023-11-09 12:15:18.455434: E tensorflow/compiler/xla/stream_executor/cuda/cuda_dnn.cc:9342] Unable to register cuDNN factory: Attempting to register factory for plugin cuDNN when one has already been registered 2023-11-09 12:15:18.455488: E tensorflow/compiler/xla/stream_executor/cuda/cuda_fft.cc:609] Unable to register cuFFT factory: Attempting to register factory for plugin cuFFT when one has already been registered 2023-11-09 12:15:18.455537: E tensorflow/compiler/xla/stream_executor/cuda/cuda_blas.cc:1518] Unable to register cuBLAS factory: Attempting to register factory for plugin cuBLAS when one has already been registered
Import required libraries from tensorflow models
import orbit
import tensorflow_models as tfm
from official.core import exp_factory
from official.core import config_definitions as cfg
from official.vision.serving import export_saved_model_lib
from official.vision.ops.preprocess_ops import normalize_image
from official.vision.ops.preprocess_ops import resize_and_crop_image
from official.vision.utils.object_detection import visualization_utils
from official.vision.dataloaders.tf_example_decoder import TfExampleDecoder
pp = pprint.PrettyPrinter(indent=4) # Set Pretty Print Indentation
print(tf.__version__) # Check the version of tensorflow used
%matplotlib inline
2.14.0
Custom dataset preparation for object detection
Models in official repository(of model-garden) requires data in a TFRecords format.
Please check this resource to learn more about TFRecords data format.
Upload your custom data in drive or local disk of the notebook and unzip the data
curl -L 'https://public.roboflow.com/ds/ZpYLqHeT0W?key=ZXfZLRnhsc' > './BCCD.v1-bccd.coco.zip'unzip -q -o './BCCD.v1-bccd.coco.zip' -d './BCC.v1-bccd.coco/'rm './BCCD.v1-bccd.coco.zip'
% Total % Received % Xferd Average Speed Time Time Time Current
Dload Upload Total Spent Left Speed
100 892 100 892 0 0 3391 0 --:--:-- --:--:-- --:--:-- 3391
100 15.2M 100 15.2M 0 0 28.7M 0 --:--:-- --:--:-- --:--:-- 288M
CLI command to convert data(train data).
TRAIN_DATA_DIR='./BCC.v1-bccd.coco/train'TRAIN_ANNOTATION_FILE_DIR='./BCC.v1-bccd.coco/train/_annotations.coco.json'OUTPUT_TFRECORD_TRAIN='./bccd_coco_tfrecords/train'# Need to provide# 1. image_dir: where images are present# 2. object_annotations_file: where annotations are listed in json format# 3. output_file_prefix: where to write output convered TFRecords filespython -m official.vision.data.create_coco_tf_record --logtostderr \--image_dir=${TRAIN_DATA_DIR} \--object_annotations_file=${TRAIN_ANNOTATION_FILE_DIR} \--output_file_prefix=$OUTPUT_TFRECORD_TRAIN \--num_shards=1
2023-11-09 12:15:24.203902: E tensorflow/compiler/xla/stream_executor/cuda/cuda_dnn.cc:9342] Unable to register cuDNN factory: Attempting to register factory for plugin cuDNN when one has already been registered 2023-11-09 12:15:24.203959: E tensorflow/compiler/xla/stream_executor/cuda/cuda_fft.cc:609] Unable to register cuFFT factory: Attempting to register factory for plugin cuFFT when one has already been registered 2023-11-09 12:15:24.203987: E tensorflow/compiler/xla/stream_executor/cuda/cuda_blas.cc:1518] Unable to register cuBLAS factory: Attempting to register factory for plugin cuBLAS when one has already been registered 2023-11-09 12:15:27.899086: W tensorflow/core/common_runtime/gpu/gpu_device.cc:2211] Cannot dlopen some GPU libraries. Please make sure the missing libraries mentioned above are installed properly if you would like to use GPU. Follow the guide at https://www.tensorflow.org/install/gpu for how to download and setup the required libraries for your platform. Skipping registering GPU devices... I1109 12:15:27.900500 140558803519296 create_coco_tf_record.py:502] writing to output path: ./bccd_coco_tfrecords/train I1109 12:15:28.110808 140558803519296 create_coco_tf_record.py:374] Building bounding box index. I1109 12:15:28.112704 140558803519296 create_coco_tf_record.py:385] 0 images are missing bboxes. I1109 12:15:28.376975 140558803519296 tfrecord_lib.py:168] On image 0 I1109 12:15:28.383184 140558803519296 tfrecord_lib.py:168] On image 100 I1109 12:15:28.388326 140558803519296 tfrecord_lib.py:168] On image 200 I1109 12:15:28.393295 140558803519296 tfrecord_lib.py:168] On image 300 I1109 12:15:28.398152 140558803519296 tfrecord_lib.py:168] On image 400 I1109 12:15:28.403067 140558803519296 tfrecord_lib.py:168] On image 500 I1109 12:15:28.407919 140558803519296 tfrecord_lib.py:168] On image 600 I1109 12:15:28.412595 140558803519296 tfrecord_lib.py:168] On image 700 I1109 12:15:28.438800 140558803519296 tfrecord_lib.py:180] Finished writing, skipped 6 annotations. I1109 12:15:28.445898 140558803519296 create_coco_tf_record.py:537] Finished writing, skipped 6 annotations.
CLI command to convert data(validation data).
VALID_DATA_DIR='./BCC.v1-bccd.coco/valid'VALID_ANNOTATION_FILE_DIR='./BCC.v1-bccd.coco/valid/_annotations.coco.json'OUTPUT_TFRECORD_VALID='./bccd_coco_tfrecords/valid'python -m official.vision.data.create_coco_tf_record --logtostderr \--image_dir=$VALID_DATA_DIR \--object_annotations_file=$VALID_ANNOTATION_FILE_DIR \--output_file_prefix=$OUTPUT_TFRECORD_VALID \--num_shards=1
2023-11-09 12:15:29.695864: E tensorflow/compiler/xla/stream_executor/cuda/cuda_dnn.cc:9342] Unable to register cuDNN factory: Attempting to register factory for plugin cuDNN when one has already been registered 2023-11-09 12:15:29.695909: E tensorflow/compiler/xla/stream_executor/cuda/cuda_fft.cc:609] Unable to register cuFFT factory: Attempting to register factory for plugin cuFFT when one has already been registered 2023-11-09 12:15:29.695940: E tensorflow/compiler/xla/stream_executor/cuda/cuda_blas.cc:1518] Unable to register cuBLAS factory: Attempting to register factory for plugin cuBLAS when one has already been registered 2023-11-09 12:15:33.418966: W tensorflow/core/common_runtime/gpu/gpu_device.cc:2211] Cannot dlopen some GPU libraries. Please make sure the missing libraries mentioned above are installed properly if you would like to use GPU. Follow the guide at https://www.tensorflow.org/install/gpu for how to download and setup the required libraries for your platform. Skipping registering GPU devices... I1109 12:15:33.419316 140466682771264 create_coco_tf_record.py:502] writing to output path: ./bccd_coco_tfrecords/valid I1109 12:15:33.426927 140466682771264 create_coco_tf_record.py:374] Building bounding box index. I1109 12:15:33.427194 140466682771264 create_coco_tf_record.py:385] 0 images are missing bboxes. I1109 12:15:33.632256 140466682771264 tfrecord_lib.py:168] On image 0 I1109 12:15:33.659518 140466682771264 tfrecord_lib.py:180] Finished writing, skipped 0 annotations. I1109 12:15:33.660955 140466682771264 create_coco_tf_record.py:537] Finished writing, skipped 0 annotations.
CLI command to convert data(test data).
TEST_DATA_DIR='./BCC.v1-bccd.coco/test'TEST_ANNOTATION_FILE_DIR='./BCC.v1-bccd.coco/test/_annotations.coco.json'OUTPUT_TFRECORD_TEST='./bccd_coco_tfrecords/test'python -m official.vision.data.create_coco_tf_record --logtostderr \--image_dir=$TEST_DATA_DIR \--object_annotations_file=$TEST_ANNOTATION_FILE_DIR \--output_file_prefix=$OUTPUT_TFRECORD_TEST \--num_shards=1
2023-11-09 12:15:34.949263: E tensorflow/compiler/xla/stream_executor/cuda/cuda_dnn.cc:9342] Unable to register cuDNN factory: Attempting to register factory for plugin cuDNN when one has already been registered 2023-11-09 12:15:34.949311: E tensorflow/compiler/xla/stream_executor/cuda/cuda_fft.cc:609] Unable to register cuFFT factory: Attempting to register factory for plugin cuFFT when one has already been registered 2023-11-09 12:15:34.949341: E tensorflow/compiler/xla/stream_executor/cuda/cuda_blas.cc:1518] Unable to register cuBLAS factory: Attempting to register factory for plugin cuBLAS when one has already been registered 2023-11-09 12:15:38.592568: W tensorflow/core/common_runtime/gpu/gpu_device.cc:2211] Cannot dlopen some GPU libraries. Please make sure the missing libraries mentioned above are installed properly if you would like to use GPU. Follow the guide at https://www.tensorflow.org/install/gpu for how to download and setup the required libraries for your platform. Skipping registering GPU devices... I1109 12:15:38.592885 140186454914880 create_coco_tf_record.py:502] writing to output path: ./bccd_coco_tfrecords/test I1109 12:15:38.596868 140186454914880 create_coco_tf_record.py:374] Building bounding box index. I1109 12:15:38.597061 140186454914880 create_coco_tf_record.py:385] 0 images are missing bboxes. I1109 12:15:38.788634 140186454914880 tfrecord_lib.py:168] On image 0 I1109 12:15:38.814095 140186454914880 tfrecord_lib.py:180] Finished writing, skipped 0 annotations. I1109 12:15:38.815249 140186454914880 create_coco_tf_record.py:537] Finished writing, skipped 0 annotations.
Configure the Retinanet Resnet FPN COCO model for custom dataset.
Dataset used for fine tuning the checkpoint is Blood Cells Detection (BCCD).
train_data_input_path = './bccd_coco_tfrecords/train-00000-of-00001.tfrecord'
valid_data_input_path = './bccd_coco_tfrecords/valid-00000-of-00001.tfrecord'
test_data_input_path = './bccd_coco_tfrecords/test-00000-of-00001.tfrecord'
model_dir = './trained_model/'
export_dir ='./exported_model/'
In Model Garden, the collections of parameters that define a model are called configs. Model Garden can create a config based on a known set of parameters via a factory.
Use the retinanet_resnetfpn_coco experiment configuration, as defined by tfm.vision.configs.retinanet.retinanet_resnetfpn_coco.
The configuration defines an experiment to train a RetinanNet with Resnet-50 as backbone, FPN as decoder. Default Configuration is trained on COCO train2017 and evaluated on COCO val2017.
There are also other alternative experiments available such as
retinanet_resnetfpn_coco, retinanet_spinenet_coco, fasterrcnn_resnetfpn_coco and more. One can switch to them by changing the experiment name argument to the get_exp_config function.
We are going to fine tune the Resnet-50 backbone checkpoint which is already present in the default configuration.
exp_config = exp_factory.get_exp_config('retinanet_resnetfpn_coco')
Adjust the model and dataset configurations so that it works with custom dataset(in this case BCCD).
batch_size = 8
num_classes = 3
HEIGHT, WIDTH = 256, 256
IMG_SIZE = [HEIGHT, WIDTH, 3]
# Backbone config.
exp_config.task.freeze_backbone = False
exp_config.task.annotation_file = ''
# Model config.
exp_config.task.model.input_size = IMG_SIZE
exp_config.task.model.num_classes = num_classes + 1
exp_config.task.model.detection_generator.tflite_post_processing.max_classes_per_detection = exp_config.task.model.num_classes
# Training data config.
exp_config.task.train_data.input_path = train_data_input_path
exp_config.task.train_data.dtype = 'float32'
exp_config.task.train_data.global_batch_size = batch_size
exp_config.task.train_data.parser.aug_scale_max = 1.0
exp_config.task.train_data.parser.aug_scale_min = 1.0
# Validation data config.
exp_config.task.validation_data.input_path = valid_data_input_path
exp_config.task.validation_data.dtype = 'float32'
exp_config.task.validation_data.global_batch_size = batch_size
Adjust the trainer configuration.
logical_device_names = [logical_device.name for logical_device in tf.config.list_logical_devices()]
if 'GPU' in ''.join(logical_device_names):
print('This may be broken in Colab.')
device = 'GPU'
elif 'TPU' in ''.join(logical_device_names):
print('This may be broken in Colab.')
device = 'TPU'
else:
print('Running on CPU is slow, so only train for a few steps.')
device = 'CPU'
train_steps = 1000
exp_config.trainer.steps_per_loop = 100 # steps_per_loop = num_of_training_examples // train_batch_size
exp_config.trainer.summary_interval = 100
exp_config.trainer.checkpoint_interval = 100
exp_config.trainer.validation_interval = 100
exp_config.trainer.validation_steps = 100 # validation_steps = num_of_validation_examples // eval_batch_size
exp_config.trainer.train_steps = train_steps
exp_config.trainer.optimizer_config.warmup.linear.warmup_steps = 100
exp_config.trainer.optimizer_config.learning_rate.type = 'cosine'
exp_config.trainer.optimizer_config.learning_rate.cosine.decay_steps = train_steps
exp_config.trainer.optimizer_config.learning_rate.cosine.initial_learning_rate = 0.1
exp_config.trainer.optimizer_config.warmup.linear.warmup_learning_rate = 0.05
Running on CPU is slow, so only train for a few steps. 2023-11-09 12:15:40.194897: W tensorflow/core/common_runtime/gpu/gpu_device.cc:2211] Cannot dlopen some GPU libraries. Please make sure the missing libraries mentioned above are installed properly if you would like to use GPU. Follow the guide at https://www.tensorflow.org/install/gpu for how to download and setup the required libraries for your platform. Skipping registering GPU devices...
Print the modified configuration.
pp.pprint(exp_config.as_dict())
display.Javascript('google.colab.output.setIframeHeight("500px");')
{ 'runtime': { 'all_reduce_alg': None,
'batchnorm_spatial_persistent': False,
'dataset_num_private_threads': None,
'default_shard_dim': -1,
'distribution_strategy': 'mirrored',
'enable_xla': False,
'gpu_thread_mode': None,
'loss_scale': None,
'mixed_precision_dtype': 'bfloat16',
'num_cores_per_replica': 1,
'num_gpus': 0,
'num_packs': 1,
'per_gpu_thread_count': 0,
'run_eagerly': False,
'task_index': -1,
'tpu': None,
'tpu_enable_xla_dynamic_padder': None,
'use_tpu_mp_strategy': False,
'worker_hosts': None},
'task': { 'allow_image_summary': False,
'annotation_file': '',
'differential_privacy_config': None,
'export_config': { 'cast_detection_classes_to_float': False,
'cast_num_detections_to_float': False,
'output_intermediate_features': False,
'output_normalized_coordinates': False},
'freeze_backbone': False,
'init_checkpoint': 'gs://cloud-tpu-checkpoints/vision-2.0/resnet50_imagenet/ckpt-28080',
'init_checkpoint_modules': 'backbone',
'losses': { 'box_loss_weight': 50,
'focal_loss_alpha': 0.25,
'focal_loss_gamma': 1.5,
'huber_loss_delta': 0.1,
'l2_weight_decay': 0.0001,
'loss_weight': 1.0},
'max_num_eval_detections': 100,
'model': { 'anchor': { 'anchor_size': 4.0,
'aspect_ratios': [0.5, 1.0, 2.0],
'num_scales': 3},
'backbone': { 'resnet': { 'bn_trainable': True,
'depth_multiplier': 1.0,
'model_id': 50,
'replace_stem_max_pool': False,
'resnetd_shortcut': False,
'scale_stem': True,
'se_ratio': 0.0,
'stem_type': 'v0',
'stochastic_depth_drop_rate': 0.0},
'type': 'resnet'},
'decoder': { 'fpn': { 'fusion_type': 'sum',
'num_filters': 256,
'use_keras_layer': False,
'use_separable_conv': False},
'type': 'fpn'},
'detection_generator': { 'apply_nms': True,
'box_coder_weights': None,
'max_num_detections': 100,
'nms_iou_threshold': 0.5,
'nms_version': 'v2',
'pre_nms_score_threshold': 0.05,
'pre_nms_top_k': 5000,
'return_decoded': None,
'soft_nms_sigma': None,
'tflite_post_processing': { 'max_classes_per_detection': 4,
'max_detections': 200,
'nms_iou_threshold': 0.5,
'nms_score_threshold': 0.1,
'normalize_anchor_coordinates': False,
'omit_nms': False,
'use_regular_nms': False},
'use_class_agnostic_nms': False,
'use_cpu_nms': False},
'head': { 'attribute_heads': [],
'num_convs': 4,
'num_filters': 256,
'share_classification_heads': False,
'share_level_convs': True,
'use_separable_conv': False},
'input_size': [256, 256, 3],
'max_level': 7,
'min_level': 3,
'norm_activation': { 'activation': 'relu',
'norm_epsilon': 0.001,
'norm_momentum': 0.99,
'use_sync_bn': False},
'num_classes': 4},
'name': None,
'per_category_metrics': False,
'train_data': { 'apply_tf_data_service_before_batching': False,
'autotune_algorithm': None,
'block_length': 1,
'cache': False,
'cycle_length': None,
'decoder': { 'simple_decoder': { 'attribute_names': [ ],
'mask_binarize_threshold': None,
'regenerate_source_id': False},
'type': 'simple_decoder'},
'deterministic': None,
'drop_remainder': True,
'dtype': 'float32',
'enable_shared_tf_data_service_between_parallel_trainers': False,
'enable_tf_data_service': False,
'file_type': 'tfrecord',
'global_batch_size': 8,
'input_path': './bccd_coco_tfrecords/train-00000-of-00001.tfrecord',
'is_training': True,
'parser': { 'aug_policy': None,
'aug_rand_hflip': True,
'aug_scale_max': 1.0,
'aug_scale_min': 1.0,
'aug_type': None,
'match_threshold': 0.5,
'max_num_instances': 100,
'num_channels': 3,
'skip_crowd_during_training': True,
'unmatched_threshold': 0.5},
'prefetch_buffer_size': None,
'seed': None,
'sharding': True,
'shuffle_buffer_size': 10000,
'tf_data_service_address': None,
'tf_data_service_job_name': None,
'tfds_as_supervised': False,
'tfds_data_dir': '',
'tfds_name': '',
'tfds_skip_decoding_feature': '',
'tfds_split': '',
'trainer_id': None,
'weights': None},
'use_coco_metrics': True,
'use_wod_metrics': False,
'validation_data': { 'apply_tf_data_service_before_batching': False,
'autotune_algorithm': None,
'block_length': 1,
'cache': False,
'cycle_length': None,
'decoder': { 'simple_decoder': { 'attribute_names': [ ],
'mask_binarize_threshold': None,
'regenerate_source_id': False},
'type': 'simple_decoder'},
'deterministic': None,
'drop_remainder': True,
'dtype': 'float32',
'enable_shared_tf_data_service_between_parallel_trainers': False,
'enable_tf_data_service': False,
'file_type': 'tfrecord',
'global_batch_size': 8,
'input_path': './bccd_coco_tfrecords/valid-00000-of-00001.tfrecord',
'is_training': False,
'parser': { 'aug_policy': None,
'aug_rand_hflip': False,
'aug_scale_max': 1.0,
'aug_scale_min': 1.0,
'aug_type': None,
'match_threshold': 0.5,
'max_num_instances': 100,
'num_channels': 3,
'skip_crowd_during_training': True,
'unmatched_threshold': 0.5},
'prefetch_buffer_size': None,
'seed': None,
'sharding': True,
'shuffle_buffer_size': 10000,
'tf_data_service_address': None,
'tf_data_service_job_name': None,
'tfds_as_supervised': False,
'tfds_data_dir': '',
'tfds_name': '',
'tfds_skip_decoding_feature': '',
'tfds_split': '',
'trainer_id': None,
'weights': None} },
'trainer': { 'allow_tpu_summary': False,
'best_checkpoint_eval_metric': '',
'best_checkpoint_export_subdir': '',
'best_checkpoint_metric_comp': 'higher',
'checkpoint_interval': 100,
'continuous_eval_timeout': 3600,
'eval_tf_function': True,
'eval_tf_while_loop': False,
'loss_upper_bound': 1000000.0,
'max_to_keep': 5,
'optimizer_config': { 'ema': None,
'learning_rate': { 'cosine': { 'alpha': 0.0,
'decay_steps': 1000,
'initial_learning_rate': 0.1,
'name': 'CosineDecay',
'offset': 0},
'type': 'cosine'},
'optimizer': { 'sgd': { 'clipnorm': None,
'clipvalue': None,
'decay': 0.0,
'global_clipnorm': None,
'momentum': 0.9,
'name': 'SGD',
'nesterov': False},
'type': 'sgd'},
'warmup': { 'linear': { 'name': 'linear',
'warmup_learning_rate': 0.05,
'warmup_steps': 100},
'type': 'linear'} },
'preemption_on_demand_checkpoint': True,
'recovery_begin_steps': 0,
'recovery_max_trials': 0,
'steps_per_loop': 100,
'summary_interval': 100,
'train_steps': 1000,
'train_tf_function': True,
'train_tf_while_loop': True,
'validation_interval': 100,
'validation_steps': 100,
'validation_summary_subdir': 'validation'} }
<IPython.core.display.Javascript object>
Set up the distribution strategy.
if exp_config.runtime.mixed_precision_dtype == tf.float16:
tf.keras.mixed_precision.set_global_policy('mixed_float16')
if 'GPU' in ''.join(logical_device_names):
distribution_strategy = tf.distribute.MirroredStrategy()
elif 'TPU' in ''.join(logical_device_names):
tf.tpu.experimental.initialize_tpu_system()
tpu = tf.distribute.cluster_resolver.TPUClusterResolver(tpu='/device:TPU_SYSTEM:0')
distribution_strategy = tf.distribute.experimental.TPUStrategy(tpu)
else:
print('Warning: this will be really slow.')
distribution_strategy = tf.distribute.OneDeviceStrategy(logical_device_names[0])
print('Done')
Warning: this will be really slow. Done
Create the Task object (tfm.core.base_task.Task) from the config_definitions.TaskConfig.
The Task object has all the methods necessary for building the dataset, building the model, and running training & evaluation. These methods are driven by tfm.core.train_lib.run_experiment.
with distribution_strategy.scope():
task = tfm.core.task_factory.get_task(exp_config.task, logging_dir=model_dir)
Visualize a batch of the data.
for images, labels in task.build_inputs(exp_config.task.train_data).take(1):
print()
print(f'images.shape: {str(images.shape):16} images.dtype: {images.dtype!r}')
print(f'labels.keys: {labels.keys()}')
images.shape: (8, 256, 256, 3) images.dtype: tf.float32 labels.keys: dict_keys(['cls_targets', 'box_targets', 'anchor_boxes', 'cls_weights', 'box_weights', 'image_info'])
Create category index dictionary to map the labels to coressponding label names.
category_index={
1: {
'id': 1,
'name': 'Platelets'
},
2: {
'id': 2,
'name': 'RBC'
},
3: {
'id': 3,
'name': 'WBC'
}
}
tf_ex_decoder = TfExampleDecoder()
Helper function for visualizing the results from TFRecords.
Use visualize_boxes_and_labels_on_image_array from visualization_utils to draw boudning boxes on the image.
def show_batch(raw_records, num_of_examples):
plt.figure(figsize=(20, 20))
use_normalized_coordinates=True
min_score_thresh = 0.30
for i, serialized_example in enumerate(raw_records):
plt.subplot(1, 3, i + 1)
decoded_tensors = tf_ex_decoder.decode(serialized_example)
image = decoded_tensors['image'].numpy().astype('uint8')
scores = np.ones(shape=(len(decoded_tensors['groundtruth_boxes'])))
visualization_utils.visualize_boxes_and_labels_on_image_array(
image,
decoded_tensors['groundtruth_boxes'].numpy(),
decoded_tensors['groundtruth_classes'].numpy().astype('int'),
scores,
category_index=category_index,
use_normalized_coordinates=use_normalized_coordinates,
max_boxes_to_draw=200,
min_score_thresh=min_score_thresh,
agnostic_mode=False,
instance_masks=None,
line_thickness=4)
plt.imshow(image)
plt.axis('off')
plt.title(f'Image-{i+1}')
plt.show()
Visualization of train data
The bounding box detection has two components
- Class label of the object detected (e.g.RBC)
- Percentage of match between predicted and ground truth bounding boxes.
buffer_size = 20
num_of_examples = 3
raw_records = tf.data.TFRecordDataset(
exp_config.task.train_data.input_path).shuffle(
buffer_size=buffer_size).take(num_of_examples)
show_batch(raw_records, num_of_examples)
Train and evaluate.
We follow the COCO challenge tradition to evaluate the accuracy of object detection based on mAP(mean Average Precision). Please check here for detail explanation of how evaluation metrics for detection task is done.
IoU: is defined as the area of the intersection divided by the area of the union of a predicted bounding box and ground truth bounding box.
model, eval_logs = tfm.core.train_lib.run_experiment(
distribution_strategy=distribution_strategy,
task=task,
mode='train_and_eval',
params=exp_config,
model_dir=model_dir,
run_post_eval=True)
restoring or initializing model...
INFO:tensorflow:Customized initialization is done through the passed `init_fn`.
INFO:tensorflow:Customized initialization is done through the passed `init_fn`.
train | step: 0 | training until step 100...
2023-11-09 12:15:53.688817: W tensorflow/core/framework/dataset.cc:959] Input of GeneratorDatasetOp::Dataset will not be optimized because the dataset does not implement the AsGraphDefInternal() method needed to apply optimizations.
train | step: 100 | steps/sec: 0.7 | output:
{'box_loss': 0.02193972,
'cls_loss': 0.6757131,
'learning_rate': 0.09755283,
'model_loss': 1.7726997,
'total_loss': 2.8906868,
'training_loss': 2.8906868}
saved checkpoint to ./trained_model/ckpt-100.
eval | step: 100 | running 100 steps of evaluation...
2023-11-09 12:18:11.406759: W tensorflow/core/framework/dataset.cc:959] Input of GeneratorDatasetOp::Dataset will not be optimized because the dataset does not implement the AsGraphDefInternal() method needed to apply optimizations.
creating index...
index created!
creating index...
index created!
Running per image evaluation...
Evaluate annotation type *bbox*
DONE (t=0.42s).
Accumulating evaluation results...
DONE (t=0.06s).
Average Precision (AP) @[ IoU=0.50:0.95 | area= all | maxDets=100 ] = 0.000
Average Precision (AP) @[ IoU=0.50 | area= all | maxDets=100 ] = 0.000
Average Precision (AP) @[ IoU=0.75 | area= all | maxDets=100 ] = 0.000
Average Precision (AP) @[ IoU=0.50:0.95 | area= small | maxDets=100 ] = 0.000
Average Precision (AP) @[ IoU=0.50:0.95 | area=medium | maxDets=100 ] = 0.000
Average Precision (AP) @[ IoU=0.50:0.95 | area= large | maxDets=100 ] = 0.000
Average Recall (AR) @[ IoU=0.50:0.95 | area= all | maxDets= 1 ] = 0.000
Average Recall (AR) @[ IoU=0.50:0.95 | area= all | maxDets= 10 ] = 0.000
Average Recall (AR) @[ IoU=0.50:0.95 | area= all | maxDets=100 ] = 0.000
Average Recall (AR) @[ IoU=0.50:0.95 | area= small | maxDets=100 ] = 0.000
Average Recall (AR) @[ IoU=0.50:0.95 | area=medium | maxDets=100 ] = 0.000
Average Recall (AR) @[ IoU=0.50:0.95 | area= large | maxDets=100 ] = 0.000
eval | step: 100 | steps/sec: 10.1 | eval time: 9.9 sec | output:
{'AP': 0.0,
'AP50': 0.0,
'AP75': 0.0,
'APl': 0.0,
'APm': 0.0,
'APs': 0.0,
'ARl': 0.0,
'ARm': 0.0,
'ARmax1': 0.0,
'ARmax10': 0.0,
'ARmax100': 0.0,
'ARs': 0.0,
'box_loss': 18.058144,
'cls_loss': 11249.595,
'model_loss': 12152.503,
'steps_per_second': 10.0835173990815,
'total_loss': 12153.81,
'validation_loss': 12153.81}
train | step: 100 | training until step 200...
train | step: 200 | steps/sec: 0.7 | output:
{'box_loss': 0.008522138,
'cls_loss': 0.50075334,
'learning_rate': 0.090450846,
'model_loss': 0.92686033,
'total_loss': 2.2234242,
'training_loss': 2.2234242}
saved checkpoint to ./trained_model/ckpt-200.
eval | step: 200 | running 100 steps of evaluation...
2023-11-09 12:20:26.584188: W tensorflow/core/framework/dataset.cc:959] Input of GeneratorDatasetOp::Dataset will not be optimized because the dataset does not implement the AsGraphDefInternal() method needed to apply optimizations.
creating index...
index created!
creating index...
index created!
Running per image evaluation...
Evaluate annotation type *bbox*
DONE (t=0.61s).
Accumulating evaluation results...
DONE (t=0.06s).
Average Precision (AP) @[ IoU=0.50:0.95 | area= all | maxDets=100 ] = 0.011
Average Precision (AP) @[ IoU=0.50 | area= all | maxDets=100 ] = 0.034
Average Precision (AP) @[ IoU=0.75 | area= all | maxDets=100 ] = 0.003
Average Precision (AP) @[ IoU=0.50:0.95 | area= small | maxDets=100 ] = 0.000
Average Precision (AP) @[ IoU=0.50:0.95 | area=medium | maxDets=100 ] = 0.010
Average Precision (AP) @[ IoU=0.50:0.95 | area= large | maxDets=100 ] = 0.059
Average Recall (AR) @[ IoU=0.50:0.95 | area= all | maxDets= 1 ] = 0.004
Average Recall (AR) @[ IoU=0.50:0.95 | area= all | maxDets= 10 ] = 0.029
Average Recall (AR) @[ IoU=0.50:0.95 | area= all | maxDets=100 ] = 0.157
Average Recall (AR) @[ IoU=0.50:0.95 | area= small | maxDets=100 ] = 0.000
Average Recall (AR) @[ IoU=0.50:0.95 | area=medium | maxDets=100 ] = 0.049
Average Recall (AR) @[ IoU=0.50:0.95 | area= large | maxDets=100 ] = 0.177
eval | step: 200 | steps/sec: 13.2 | eval time: 7.6 sec | output:
{'AP': 0.010944664,
'AP50': 0.03427069,
'AP75': 0.0026895092,
'APl': 0.05921977,
'APm': 0.01015669,
'APs': 0.0,
'ARl': 0.17723133,
'ARm': 0.048520368,
'ARmax1': 0.0035891088,
'ARmax10': 0.029232906,
'ARmax100': 0.15689641,
'ARs': 0.0,
'box_loss': 0.009609308,
'cls_loss': 4.135805,
'model_loss': 4.61627,
'steps_per_second': 13.19492688372793,
'total_loss': 5.900796,
'validation_loss': 5.900796}
train | step: 200 | training until step 300...
train | step: 300 | steps/sec: 0.8 | output:
{'box_loss': 0.00830541,
'cls_loss': 0.4176439,
'learning_rate': 0.07938927,
'model_loss': 0.8329147,
'total_loss': 2.1065934,
'training_loss': 2.1065934}
saved checkpoint to ./trained_model/ckpt-300.
eval | step: 300 | running 100 steps of evaluation...
2023-11-09 12:22:38.377585: W tensorflow/core/framework/dataset.cc:959] Input of GeneratorDatasetOp::Dataset will not be optimized because the dataset does not implement the AsGraphDefInternal() method needed to apply optimizations.
creating index...
index created!
creating index...
index created!
Running per image evaluation...
Evaluate annotation type *bbox*
DONE (t=1.35s).
Accumulating evaluation results...
DONE (t=0.06s).
Average Precision (AP) @[ IoU=0.50:0.95 | area= all | maxDets=100 ] = 0.016
Average Precision (AP) @[ IoU=0.50 | area= all | maxDets=100 ] = 0.069
Average Precision (AP) @[ IoU=0.75 | area= all | maxDets=100 ] = 0.002
Average Precision (AP) @[ IoU=0.50:0.95 | area= small | maxDets=100 ] = 0.000
Average Precision (AP) @[ IoU=0.50:0.95 | area=medium | maxDets=100 ] = 0.013
Average Precision (AP) @[ IoU=0.50:0.95 | area= large | maxDets=100 ] = 0.009
Average Recall (AR) @[ IoU=0.50:0.95 | area= all | maxDets= 1 ] = 0.032
Average Recall (AR) @[ IoU=0.50:0.95 | area= all | maxDets= 10 ] = 0.063
Average Recall (AR) @[ IoU=0.50:0.95 | area= all | maxDets=100 ] = 0.141
Average Recall (AR) @[ IoU=0.50:0.95 | area= small | maxDets=100 ] = 0.000
Average Recall (AR) @[ IoU=0.50:0.95 | area=medium | maxDets=100 ] = 0.100
Average Recall (AR) @[ IoU=0.50:0.95 | area= large | maxDets=100 ] = 0.124
eval | step: 300 | steps/sec: 12.5 | eval time: 8.0 sec | output:
{'AP': 0.016204117,
'AP50': 0.06889212,
'AP75': 0.0020602986,
'APl': 0.009428242,
'APm': 0.013351731,
'APs': 0.0,
'ARl': 0.123588346,
'ARm': 0.10017456,
'ARmax1': 0.03215091,
'ARmax10': 0.063206546,
'ARmax100': 0.14125936,
'ARs': 0.0,
'box_loss': 0.00870863,
'cls_loss': 0.5394852,
'model_loss': 0.97491676,
'steps_per_second': 12.503431188892941,
'total_loss': 2.2379956,
'validation_loss': 2.2379956}
train | step: 300 | training until step 400...
train | step: 400 | steps/sec: 0.8 | output:
{'box_loss': 0.008178472,
'cls_loss': 0.39109412,
'learning_rate': 0.06545085,
'model_loss': 0.8000177,
'total_loss': 2.05375,
'training_loss': 2.05375}
saved checkpoint to ./trained_model/ckpt-400.
eval | step: 400 | running 100 steps of evaluation...
2023-11-09 12:24:51.305428: W tensorflow/core/framework/dataset.cc:959] Input of GeneratorDatasetOp::Dataset will not be optimized because the dataset does not implement the AsGraphDefInternal() method needed to apply optimizations.
creating index...
index created!
creating index...
index created!
Running per image evaluation...
Evaluate annotation type *bbox*
DONE (t=1.32s).
Accumulating evaluation results...
DONE (t=0.06s).
Average Precision (AP) @[ IoU=0.50:0.95 | area= all | maxDets=100 ] = 0.170
Average Precision (AP) @[ IoU=0.50 | area= all | maxDets=100 ] = 0.417
Average Precision (AP) @[ IoU=0.75 | area= all | maxDets=100 ] = 0.080
Average Precision (AP) @[ IoU=0.50:0.95 | area= small | maxDets=100 ] = 0.000
Average Precision (AP) @[ IoU=0.50:0.95 | area=medium | maxDets=100 ] = 0.126
Average Precision (AP) @[ IoU=0.50:0.95 | area= large | maxDets=100 ] = 0.164
Average Recall (AR) @[ IoU=0.50:0.95 | area= all | maxDets= 1 ] = 0.139
Average Recall (AR) @[ IoU=0.50:0.95 | area= all | maxDets= 10 ] = 0.211
Average Recall (AR) @[ IoU=0.50:0.95 | area= all | maxDets=100 ] = 0.289
Average Recall (AR) @[ IoU=0.50:0.95 | area= small | maxDets=100 ] = 0.000
Average Recall (AR) @[ IoU=0.50:0.95 | area=medium | maxDets=100 ] = 0.223
Average Recall (AR) @[ IoU=0.50:0.95 | area= large | maxDets=100 ] = 0.265
eval | step: 400 | steps/sec: 12.5 | eval time: 8.0 sec | output:
{'AP': 0.16998358,
'AP50': 0.41680792,
'AP75': 0.07954546,
'APl': 0.16424511,
'APm': 0.12631872,
'APs': 0.0,
'ARl': 0.26493624,
'ARm': 0.22271821,
'ARmax1': 0.13854705,
'ARmax10': 0.2114396,
'ARmax100': 0.2887498,
'ARs': 0.0,
'box_loss': 0.007682202,
'cls_loss': 0.44814157,
'model_loss': 0.8322517,
'steps_per_second': 12.476437706321125,
'total_loss': 2.0770469,
'validation_loss': 2.0770469}
train | step: 400 | training until step 500...
train | step: 500 | steps/sec: 0.8 | output:
{'box_loss': 0.008003844,
'cls_loss': 0.37224656,
'learning_rate': 0.049999997,
'model_loss': 0.77243865,
'total_loss': 2.0097175,
'training_loss': 2.0097175}
saved checkpoint to ./trained_model/ckpt-500.
eval | step: 500 | running 100 steps of evaluation...
2023-11-09 12:27:03.978075: W tensorflow/core/framework/dataset.cc:959] Input of GeneratorDatasetOp::Dataset will not be optimized because the dataset does not implement the AsGraphDefInternal() method needed to apply optimizations.
creating index...
index created!
creating index...
index created!
Running per image evaluation...
Evaluate annotation type *bbox*
DONE (t=1.31s).
Accumulating evaluation results...
DONE (t=0.06s).
Average Precision (AP) @[ IoU=0.50:0.95 | area= all | maxDets=100 ] = 0.144
Average Precision (AP) @[ IoU=0.50 | area= all | maxDets=100 ] = 0.409
Average Precision (AP) @[ IoU=0.75 | area= all | maxDets=100 ] = 0.018
Average Precision (AP) @[ IoU=0.50:0.95 | area= small | maxDets=100 ] = 0.000
Average Precision (AP) @[ IoU=0.50:0.95 | area=medium | maxDets=100 ] = 0.068
Average Precision (AP) @[ IoU=0.50:0.95 | area= large | maxDets=100 ] = 0.146
Average Recall (AR) @[ IoU=0.50:0.95 | area= all | maxDets= 1 ] = 0.141
Average Recall (AR) @[ IoU=0.50:0.95 | area= all | maxDets= 10 ] = 0.177
Average Recall (AR) @[ IoU=0.50:0.95 | area= all | maxDets=100 ] = 0.249
Average Recall (AR) @[ IoU=0.50:0.95 | area= small | maxDets=100 ] = 0.000
Average Recall (AR) @[ IoU=0.50:0.95 | area=medium | maxDets=100 ] = 0.163
Average Recall (AR) @[ IoU=0.50:0.95 | area= large | maxDets=100 ] = 0.228
eval | step: 500 | steps/sec: 12.6 | eval time: 8.0 sec | output:
{'AP': 0.14389119,
'AP50': 0.40903544,
'AP75': 0.01820877,
'APl': 0.14554419,
'APm': 0.06774697,
'APs': 0.0,
'ARl': 0.22750455,
'ARm': 0.16317539,
'ARmax1': 0.14100254,
'ARmax10': 0.17656359,
'ARmax100': 0.24859329,
'ARs': 0.0,
'box_loss': 0.008371367,
'cls_loss': 0.46203443,
'model_loss': 0.8806029,
'steps_per_second': 12.550521613819056,
'total_loss': 2.110864,
'validation_loss': 2.110864}
train | step: 500 | training until step 600...
train | step: 600 | steps/sec: 0.8 | output:
{'box_loss': 0.0075427825,
'cls_loss': 0.36228406,
'learning_rate': 0.034549143,
'model_loss': 0.739423,
'total_loss': 1.9641409,
'training_loss': 1.9641409}
saved checkpoint to ./trained_model/ckpt-600.
eval | step: 600 | running 100 steps of evaluation...
2023-11-09 12:29:16.661897: W tensorflow/core/framework/dataset.cc:959] Input of GeneratorDatasetOp::Dataset will not be optimized because the dataset does not implement the AsGraphDefInternal() method needed to apply optimizations.
creating index...
index created!
creating index...
index created!
Running per image evaluation...
Evaluate annotation type *bbox*
DONE (t=1.26s).
Accumulating evaluation results...
DONE (t=0.06s).
Average Precision (AP) @[ IoU=0.50:0.95 | area= all | maxDets=100 ] = 0.205
Average Precision (AP) @[ IoU=0.50 | area= all | maxDets=100 ] = 0.494
Average Precision (AP) @[ IoU=0.75 | area= all | maxDets=100 ] = 0.074
Average Precision (AP) @[ IoU=0.50:0.95 | area= small | maxDets=100 ] = 0.000
Average Precision (AP) @[ IoU=0.50:0.95 | area=medium | maxDets=100 ] = 0.165
Average Precision (AP) @[ IoU=0.50:0.95 | area= large | maxDets=100 ] = 0.210
Average Recall (AR) @[ IoU=0.50:0.95 | area= all | maxDets= 1 ] = 0.178
Average Recall (AR) @[ IoU=0.50:0.95 | area= all | maxDets= 10 ] = 0.249
Average Recall (AR) @[ IoU=0.50:0.95 | area= all | maxDets=100 ] = 0.304
Average Recall (AR) @[ IoU=0.50:0.95 | area= small | maxDets=100 ] = 0.000
Average Recall (AR) @[ IoU=0.50:0.95 | area=medium | maxDets=100 ] = 0.288
Average Recall (AR) @[ IoU=0.50:0.95 | area= large | maxDets=100 ] = 0.281
eval | step: 600 | steps/sec: 12.3 | eval time: 8.1 sec | output:
{'AP': 0.20549679,
'AP50': 0.49406928,
'AP75': 0.074281454,
'APl': 0.20956378,
'APm': 0.16475147,
'APs': 0.0,
'ARl': 0.2809654,
'ARm': 0.28829592,
'ARmax1': 0.17803712,
'ARmax10': 0.24863629,
'ARmax100': 0.3042056,
'ARs': 0.0,
'box_loss': 0.007942874,
'cls_loss': 0.3965486,
'model_loss': 0.79369235,
'steps_per_second': 12.345320504588557,
'total_loss': 2.013407,
'validation_loss': 2.013407}
train | step: 600 | training until step 700...
train | step: 700 | steps/sec: 0.8 | output:
{'box_loss': 0.007070377,
'cls_loss': 0.34681392,
'learning_rate': 0.02061074,
'model_loss': 0.7003328,
'total_loss': 1.91634,
'training_loss': 1.91634}
saved checkpoint to ./trained_model/ckpt-700.
eval | step: 700 | running 100 steps of evaluation...
2023-11-09 12:31:29.396952: W tensorflow/core/framework/dataset.cc:959] Input of GeneratorDatasetOp::Dataset will not be optimized because the dataset does not implement the AsGraphDefInternal() method needed to apply optimizations.
creating index...
index created!
creating index...
index created!
Running per image evaluation...
Evaluate annotation type *bbox*
DONE (t=1.25s).
Accumulating evaluation results...
DONE (t=0.06s).
Average Precision (AP) @[ IoU=0.50:0.95 | area= all | maxDets=100 ] = 0.266
Average Precision (AP) @[ IoU=0.50 | area= all | maxDets=100 ] = 0.548
Average Precision (AP) @[ IoU=0.75 | area= all | maxDets=100 ] = 0.195
Average Precision (AP) @[ IoU=0.50:0.95 | area= small | maxDets=100 ] = 0.000
Average Precision (AP) @[ IoU=0.50:0.95 | area=medium | maxDets=100 ] = 0.211
Average Precision (AP) @[ IoU=0.50:0.95 | area= large | maxDets=100 ] = 0.320
Average Recall (AR) @[ IoU=0.50:0.95 | area= all | maxDets= 1 ] = 0.199
Average Recall (AR) @[ IoU=0.50:0.95 | area= all | maxDets= 10 ] = 0.293
Average Recall (AR) @[ IoU=0.50:0.95 | area= all | maxDets=100 ] = 0.354
Average Recall (AR) @[ IoU=0.50:0.95 | area= small | maxDets=100 ] = 0.000
Average Recall (AR) @[ IoU=0.50:0.95 | area=medium | maxDets=100 ] = 0.314
Average Recall (AR) @[ IoU=0.50:0.95 | area= large | maxDets=100 ] = 0.339
eval | step: 700 | steps/sec: 12.4 | eval time: 8.0 sec | output:
{'AP': 0.26574683,
'AP50': 0.54845077,
'AP75': 0.19461285,
'APl': 0.3196148,
'APm': 0.21140255,
'APs': 0.0,
'ARl': 0.33888888,
'ARm': 0.31413966,
'ARmax1': 0.19884779,
'ARmax10': 0.29322097,
'ARmax100': 0.35407078,
'ARs': 0.0,
'box_loss': 0.006610607,
'cls_loss': 0.35634473,
'model_loss': 0.68687505,
'steps_per_second': 12.437609994369083,
'total_loss': 1.8996844,
'validation_loss': 1.8996844}
train | step: 700 | training until step 800...
train | step: 800 | steps/sec: 0.8 | output:
{'box_loss': 0.006680321,
'cls_loss': 0.3391388,
'learning_rate': 0.009549147,
'model_loss': 0.673155,
'total_loss': 1.8838484,
'training_loss': 1.8838484}
saved checkpoint to ./trained_model/ckpt-800.
eval | step: 800 | running 100 steps of evaluation...
2023-11-09 12:33:41.871412: W tensorflow/core/framework/dataset.cc:959] Input of GeneratorDatasetOp::Dataset will not be optimized because the dataset does not implement the AsGraphDefInternal() method needed to apply optimizations.
creating index...
index created!
creating index...
index created!
Running per image evaluation...
Evaluate annotation type *bbox*
DONE (t=1.21s).
Accumulating evaluation results...
DONE (t=0.06s).
Average Precision (AP) @[ IoU=0.50:0.95 | area= all | maxDets=100 ] = 0.270
Average Precision (AP) @[ IoU=0.50 | area= all | maxDets=100 ] = 0.551
Average Precision (AP) @[ IoU=0.75 | area= all | maxDets=100 ] = 0.228
Average Precision (AP) @[ IoU=0.50:0.95 | area= small | maxDets=100 ] = 0.000
Average Precision (AP) @[ IoU=0.50:0.95 | area=medium | maxDets=100 ] = 0.238
Average Precision (AP) @[ IoU=0.50:0.95 | area= large | maxDets=100 ] = 0.293
Average Recall (AR) @[ IoU=0.50:0.95 | area= all | maxDets= 1 ] = 0.203
Average Recall (AR) @[ IoU=0.50:0.95 | area= all | maxDets= 10 ] = 0.292
Average Recall (AR) @[ IoU=0.50:0.95 | area= all | maxDets=100 ] = 0.355
Average Recall (AR) @[ IoU=0.50:0.95 | area= small | maxDets=100 ] = 0.000
Average Recall (AR) @[ IoU=0.50:0.95 | area=medium | maxDets=100 ] = 0.330
Average Recall (AR) @[ IoU=0.50:0.95 | area= large | maxDets=100 ] = 0.310
eval | step: 800 | steps/sec: 12.2 | eval time: 8.2 sec | output:
{'AP': 0.27034393,
'AP50': 0.55116975,
'AP75': 0.22773828,
'APl': 0.29330468,
'APm': 0.23779006,
'APs': 0.0,
'ARl': 0.30956283,
'ARm': 0.33016625,
'ARmax1': 0.2025409,
'ARmax10': 0.29244527,
'ARmax100': 0.35519278,
'ARs': 0.0,
'box_loss': 0.006337466,
'cls_loss': 0.3529123,
'model_loss': 0.6697856,
'steps_per_second': 12.213763576089187,
'total_loss': 1.8787861,
'validation_loss': 1.8787861}
train | step: 800 | training until step 900...
train | step: 900 | steps/sec: 0.8 | output:
{'box_loss': 0.006552434,
'cls_loss': 0.3347254,
'learning_rate': 0.002447176,
'model_loss': 0.6623471,
'total_loss': 1.8704419,
'training_loss': 1.8704419}
saved checkpoint to ./trained_model/ckpt-900.
eval | step: 900 | running 100 steps of evaluation...
2023-11-09 12:35:54.334538: W tensorflow/core/framework/dataset.cc:959] Input of GeneratorDatasetOp::Dataset will not be optimized because the dataset does not implement the AsGraphDefInternal() method needed to apply optimizations.
creating index...
index created!
creating index...
index created!
Running per image evaluation...
Evaluate annotation type *bbox*
DONE (t=1.22s).
Accumulating evaluation results...
DONE (t=0.06s).
Average Precision (AP) @[ IoU=0.50:0.95 | area= all | maxDets=100 ] = 0.265
Average Precision (AP) @[ IoU=0.50 | area= all | maxDets=100 ] = 0.563
Average Precision (AP) @[ IoU=0.75 | area= all | maxDets=100 ] = 0.146
Average Precision (AP) @[ IoU=0.50:0.95 | area= small | maxDets=100 ] = 0.000
Average Precision (AP) @[ IoU=0.50:0.95 | area=medium | maxDets=100 ] = 0.261
Average Precision (AP) @[ IoU=0.50:0.95 | area= large | maxDets=100 ] = 0.306
Average Recall (AR) @[ IoU=0.50:0.95 | area= all | maxDets= 1 ] = 0.197
Average Recall (AR) @[ IoU=0.50:0.95 | area= all | maxDets= 10 ] = 0.290
Average Recall (AR) @[ IoU=0.50:0.95 | area= all | maxDets=100 ] = 0.348
Average Recall (AR) @[ IoU=0.50:0.95 | area= small | maxDets=100 ] = 0.000
Average Recall (AR) @[ IoU=0.50:0.95 | area=medium | maxDets=100 ] = 0.344
Average Recall (AR) @[ IoU=0.50:0.95 | area= large | maxDets=100 ] = 0.326
eval | step: 900 | steps/sec: 12.2 | eval time: 8.2 sec | output:
{'AP': 0.26503274,
'AP50': 0.5632806,
'AP75': 0.1462794,
'APl': 0.30633608,
'APm': 0.26065546,
'APs': 0.0,
'ARl': 0.3263206,
'ARm': 0.34426433,
'ARmax1': 0.19695416,
'ARmax10': 0.28974226,
'ARmax100': 0.3476218,
'ARs': 0.0,
'box_loss': 0.006341949,
'cls_loss': 0.3344063,
'model_loss': 0.6515038,
'steps_per_second': 12.173977857621107,
'total_loss': 1.8589785,
'validation_loss': 1.8589785}
train | step: 900 | training until step 1000...
train | step: 1000 | steps/sec: 0.8 | output:
{'box_loss': 0.0064173574,
'cls_loss': 0.33288643,
'learning_rate': 0.0,
'model_loss': 0.6537543,
'total_loss': 1.8610404,
'training_loss': 1.8610404}
saved checkpoint to ./trained_model/ckpt-1000.
eval | step: 1000 | running 100 steps of evaluation...
2023-11-09 12:38:06.900922: W tensorflow/core/framework/dataset.cc:959] Input of GeneratorDatasetOp::Dataset will not be optimized because the dataset does not implement the AsGraphDefInternal() method needed to apply optimizations.
creating index...
index created!
creating index...
index created!
Running per image evaluation...
Evaluate annotation type *bbox*
DONE (t=1.22s).
Accumulating evaluation results...
DONE (t=0.06s).
Average Precision (AP) @[ IoU=0.50:0.95 | area= all | maxDets=100 ] = 0.258
Average Precision (AP) @[ IoU=0.50 | area= all | maxDets=100 ] = 0.554
Average Precision (AP) @[ IoU=0.75 | area= all | maxDets=100 ] = 0.137
Average Precision (AP) @[ IoU=0.50:0.95 | area= small | maxDets=100 ] = 0.000
Average Precision (AP) @[ IoU=0.50:0.95 | area=medium | maxDets=100 ] = 0.247
Average Precision (AP) @[ IoU=0.50:0.95 | area= large | maxDets=100 ] = 0.298
Average Recall (AR) @[ IoU=0.50:0.95 | area= all | maxDets= 1 ] = 0.193
Average Recall (AR) @[ IoU=0.50:0.95 | area= all | maxDets= 10 ] = 0.287
Average Recall (AR) @[ IoU=0.50:0.95 | area= all | maxDets=100 ] = 0.344
Average Recall (AR) @[ IoU=0.50:0.95 | area= small | maxDets=100 ] = 0.000
Average Recall (AR) @[ IoU=0.50:0.95 | area=medium | maxDets=100 ] = 0.329
Average Recall (AR) @[ IoU=0.50:0.95 | area= large | maxDets=100 ] = 0.324
eval | step: 1000 | steps/sec: 11.6 | eval time: 8.6 sec | output:
{'AP': 0.25785798,
'AP50': 0.5541018,
'AP75': 0.13742597,
'APl': 0.29831147,
'APm': 0.24709457,
'APs': 0.0,
'ARl': 0.32358834,
'ARm': 0.3290108,
'ARmax1': 0.19289383,
'ARmax10': 0.28744015,
'ARmax100': 0.3443296,
'ARs': 0.0,
'box_loss': 0.006123655,
'cls_loss': 0.3268734,
'model_loss': 0.6330561,
'steps_per_second': 11.647036187140033,
'total_loss': 1.8402674,
'validation_loss': 1.8402674}
eval | step: 1000 | running 100 steps of evaluation...
creating index...
index created!
creating index...
index created!
Running per image evaluation...
Evaluate annotation type *bbox*
DONE (t=1.21s).
Accumulating evaluation results...
DONE (t=0.06s).
Average Precision (AP) @[ IoU=0.50:0.95 | area= all | maxDets=100 ] = 0.258
Average Precision (AP) @[ IoU=0.50 | area= all | maxDets=100 ] = 0.554
Average Precision (AP) @[ IoU=0.75 | area= all | maxDets=100 ] = 0.137
Average Precision (AP) @[ IoU=0.50:0.95 | area= small | maxDets=100 ] = 0.000
Average Precision (AP) @[ IoU=0.50:0.95 | area=medium | maxDets=100 ] = 0.247
Average Precision (AP) @[ IoU=0.50:0.95 | area= large | maxDets=100 ] = 0.298
Average Recall (AR) @[ IoU=0.50:0.95 | area= all | maxDets= 1 ] = 0.193
Average Recall (AR) @[ IoU=0.50:0.95 | area= all | maxDets= 10 ] = 0.287
Average Recall (AR) @[ IoU=0.50:0.95 | area= all | maxDets=100 ] = 0.344
Average Recall (AR) @[ IoU=0.50:0.95 | area= small | maxDets=100 ] = 0.000
Average Recall (AR) @[ IoU=0.50:0.95 | area=medium | maxDets=100 ] = 0.329
Average Recall (AR) @[ IoU=0.50:0.95 | area= large | maxDets=100 ] = 0.324
eval | step: 1000 | steps/sec: 12.1 | eval time: 8.2 sec | output:
{'AP': 0.25785798,
'AP50': 0.5541018,
'AP75': 0.13742597,
'APl': 0.29831147,
'APm': 0.24709457,
'APs': 0.0,
'ARl': 0.32358834,
'ARm': 0.3290108,
'ARmax1': 0.19289383,
'ARmax10': 0.28744015,
'ARmax100': 0.3443296,
'ARs': 0.0,
'box_loss': 0.006123655,
'cls_loss': 0.3268734,
'model_loss': 0.6330561,
'steps_per_second': 12.140613310097448,
'total_loss': 1.8402674,
'validation_loss': 1.8402674}
Load logs in tensorboard.
%load_ext tensorboard
%tensorboard --logdir './trained_model/'
Saving and exporting the trained model.
The keras.Model object returned by train_lib.run_experiment expects the data to be normalized by the dataset loader using the same mean and variance statiscics in preprocess_ops.normalize_image(image, offset=MEAN_RGB, scale=STDDEV_RGB). This export function handles those details, so you can pass tf.uint8 images and get the correct results.
export_saved_model_lib.export_inference_graph(
input_type='image_tensor',
batch_size=1,
input_image_size=[HEIGHT, WIDTH],
params=exp_config,
checkpoint_path=tf.train.latest_checkpoint(model_dir),
export_dir=export_dir)
WARNING:tensorflow:Skipping full serialization of Keras layer <official.vision.modeling.retinanet_model.RetinaNetModel object at 0x7f29ec799a90>, because it is not built. WARNING:tensorflow:Skipping full serialization of Keras layer <official.vision.modeling.retinanet_model.RetinaNetModel object at 0x7f29ec799a90>, because it is not built. WARNING:tensorflow:Skipping full serialization of Keras layer <official.vision.modeling.layers.detection_generator.MultilevelDetectionGenerator object at 0x7f2a30060940>, because it is not built. WARNING:tensorflow:Skipping full serialization of Keras layer <official.vision.modeling.layers.detection_generator.MultilevelDetectionGenerator object at 0x7f2a30060940>, because it is not built. INFO:tensorflow:Assets written to: ./exported_model/assets INFO:tensorflow:Assets written to: ./exported_model/assets
Inference from trained model
def load_image_into_numpy_array(path):
"""Load an image from file into a numpy array.
Puts image into numpy array to feed into tensorflow graph.
Note that by convention we put it into a numpy array with shape
(height, width, channels), where channels=3 for RGB.
Args:
path: the file path to the image
Returns:
uint8 numpy array with shape (img_height, img_width, 3)
"""
image = None
if(path.startswith('http')):
response = urlopen(path)
image_data = response.read()
image_data = BytesIO(image_data)
image = Image.open(image_data)
else:
image_data = tf.io.gfile.GFile(path, 'rb').read()
image = Image.open(BytesIO(image_data))
(im_width, im_height) = image.size
return np.array(image.getdata()).reshape(
(1, im_height, im_width, 3)).astype(np.uint8)
def build_inputs_for_object_detection(image, input_image_size):
"""Builds Object Detection model inputs for serving."""
image, _ = resize_and_crop_image(
image,
input_image_size,
padded_size=input_image_size,
aug_scale_min=1.0,
aug_scale_max=1.0)
return image
Visualize test data.
num_of_examples = 3
test_ds = tf.data.TFRecordDataset(
'./bccd_coco_tfrecords/test-00000-of-00001.tfrecord').take(
num_of_examples)
show_batch(test_ds, num_of_examples)

Importing SavedModel.
imported = tf.saved_model.load(export_dir)
model_fn = imported.signatures['serving_default']
Visualize predictions.
input_image_size = (HEIGHT, WIDTH)
plt.figure(figsize=(20, 20))
min_score_thresh = 0.30 # Change minimum score for threshold to see all bounding boxes confidences.
for i, serialized_example in enumerate(test_ds):
plt.subplot(1, 3, i+1)
decoded_tensors = tf_ex_decoder.decode(serialized_example)
image = build_inputs_for_object_detection(decoded_tensors['image'], input_image_size)
image = tf.expand_dims(image, axis=0)
image = tf.cast(image, dtype = tf.uint8)
image_np = image[0].numpy()
result = model_fn(image)
visualization_utils.visualize_boxes_and_labels_on_image_array(
image_np,
result['detection_boxes'][0].numpy(),
result['detection_classes'][0].numpy().astype(int),
result['detection_scores'][0].numpy(),
category_index=category_index,
use_normalized_coordinates=False,
max_boxes_to_draw=200,
min_score_thresh=min_score_thresh,
agnostic_mode=False,
instance_masks=None,
line_thickness=4)
plt.imshow(image_np)
plt.axis('off')
plt.show()

View on TensorFlow.org
Run in Google Colab
View on GitHub
Download notebook